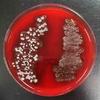

| ||||
Science Image Library: Blood Agar (BAP) Photos
Science Image Library
Blood Agar Bacterial Growth Medium
from Science Prof Online
Beta-hemolysis patterns on Blood Agar best viewed from underside of plate.
1. Bottom of sterile plate of BAP. The bottom of a BAP plate with Gamma-hemolytic bacteria would look the same; 2. Sterile plate of BAP with camera reflected; 3. Sterile, labeled plate of blood agar; 4. Sterile MacComkey's agar, Mannitol Salt agar and Blood agar (clockwise from top left).
 | ||||
You have free access to a large collection of materials used in a college-level introductory microbiology course!
Beta-Hemolysis on Blood Agar (Click on image to enlarge.)
Alpha-Hemolysis on Blood Agar (Click on image to enlarge.)
Sterile Plates of Blood Agar (Click on image to enlarge.)
Alpha-hemolysis patterns on Blood Agar best viewed from underside of plate.
Page last updated: 5/2014
Didn't find what you need?
Search SPO for a Photo
SPO VIRTUAL CLASSROOMS
 | ||||||
 | ||||||
SPO is a FREE science education website. Donations are key in helping us provide this resource with fewer ads.
Please help!
(This donation link uses PayPal on a secure connection.)
SCIENCE VIDEOS
The Microbiology Image Library is the largest photo collection on the SPO site. To help you more easily find what you're looking for, select the "See more" link of the sub-topic below that corresponds to your interests or use the search boxes.
The SPO Science Image Library is a continuously growing collection of copyright-free science photographs. If you use one of our free, low-res images, we just ask that you give us credit and provide a link to the SPO website (scienceprofonline.com). Click on photo to enlarge. To save a photo to your computer, right click on it and select "Save".
For those in need of high-resolution images, we will soon be offering hi-res files of many photos in the Science Image Library. Follow us on Twitter @ScienceProfSPO to get updates on new SPO features and products. If you need a high resolution photo now, please contact us.